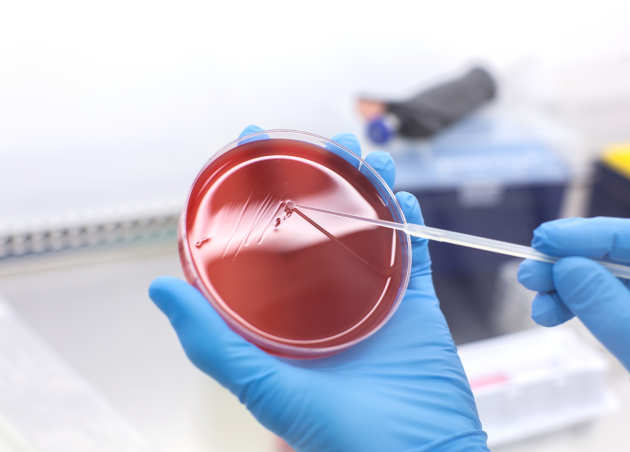

Add alternative (alt) text to images
Just as you would do for a web page, all images on your documents must have a text alternative. This is to enable visually impaired people using screen readers to understand what the image is. There is more about the reasons for this on our Text alternatives for images page.
How to add alt text
These instructions apply to Word, Excel and PowerPoint.
1. Click on your image
2.
a) If using Office 365 or Windows then right click and select Format Picture and click on Layout & Properties and select Alt Text.

b) If using a Mac then right click and Select Edit Alt Text… or click on the Alt Text icon on the ‘ribbon’ bar at the top of the page.

3. Enter a description of the image in the box. On Windows or Office365 this is referred to as the ‘Description’.
You may also see a 'Title' box, where you can add a title for the image. This should be short whereas the alt text is more descriptive.
Example
In this case a good alt-text (description) would be:
"A scientist holding a petri dish and inoculating a blood agar plate in the Biological Safety Cabinet."
Further guidance
For more guidance on writing alt text, see our Text alternatives for images page.